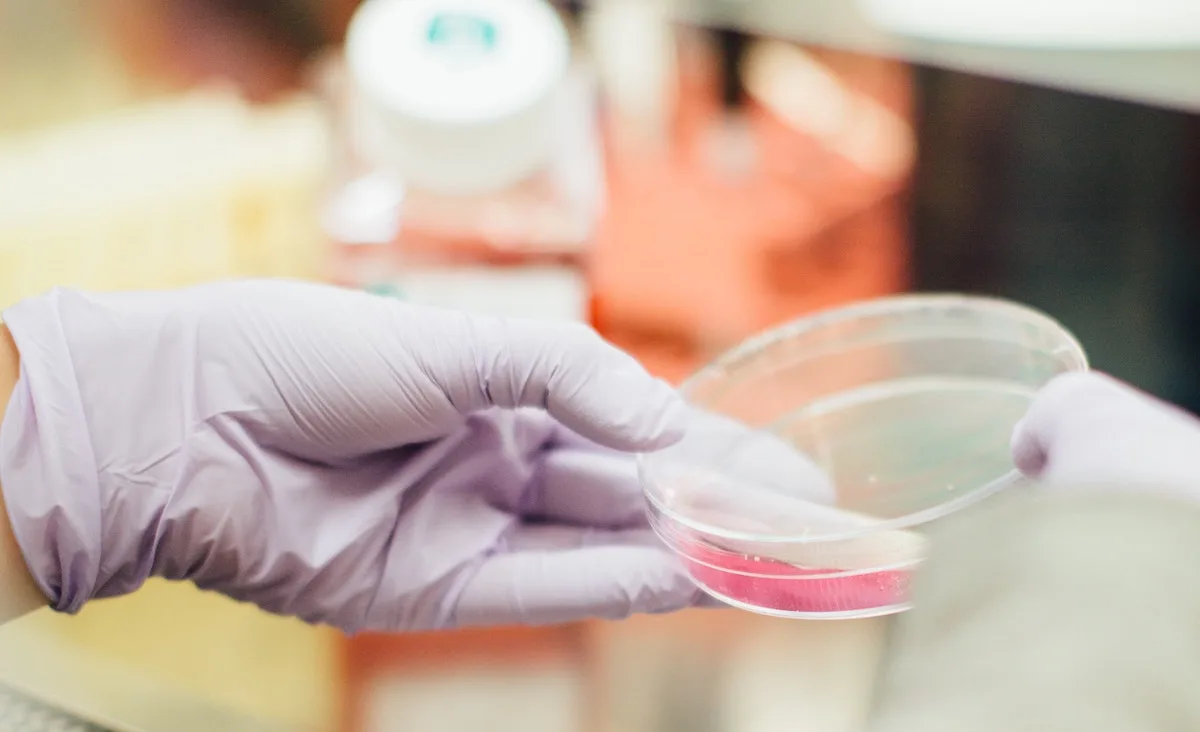
fashion product testing

Lessons Learned from Launching a Fashion Fine Jewellery Brand
If you want to discover what invaluable lessons I learned from launching a fashion fine jewellery brand, then read on. It is often said that

If you want to discover what invaluable lessons I learned from launching a fashion fine jewellery brand, then read on. It is often said that

Fashion pricing strategy is one of the most challenging areas for fashion apparel and accessories brands. For the most part, the challenge is due to

To launch a fashion brand to a specific niche of customers or market is an age-old tested recipe for business success. To grow your fashion

When starting a fashion business, much like starting any business, there are some rules that apply and are there for a reason. Rule number one

Providing factories with a “Technical Drawing” otherwise known as a “Flat Drawing” is one of the essential requirements when manufacturing garments or accessories. Whether you
Fashion product testing Furthermore enables the reduction of risks such as product recalls, helps protect your brand and gain the trust of the consumer. Learn what are the basic tests you should perform for your product.

Care instruction cards are an excellent way to communicate your brand values and educate your customer about your product, especially if your products are handmade or use any specialist materials.

As a fashion designer, exploring the options in regards to manufacturing, there are many things to consider. One of the hardest and most important decisions would be how to get your bulk production made. Learn how successful brands do it and the two most widely used methods they work to.

Before embarking on production for your fashion start-up, you will no doubt research the differences between manufacturing locally or offshore. Costs will surely be at the forefront of your mind, but there are so many other things to consider.

Wanting to launch your own fashion brand is on the wish list of many fashionistas. While many dream about it, only a few get to see their idea realised on paper. The fashion design process takes time and what may have seemed like a simple idea at the start turns into Pandora’s box.

Ever thought of starting a fashion label? Many do – every day and as soon as they think about it, their heads get inundated with questions… Questions about the design process in general like… Do ideas come from inspiration or from materials? What is the best way to go about designing a collection?

Starting your own brand can be the most exciting thing in the world. Designing your dream line and the prestige of selling your collections in renowned stores are surely very enticing. However, the reality of setting up shop will be something entirely different to your initial perceived idea. Read up and find out what is vitally important to know before you start.

In the 1940s the Toyota Motor Company pioneered a type of manufacturing called “Just-In-Time.” Its objective was to eliminate waste, inconsistencies, and unreasonable requirements from the production process, thus resulting in improved productivity. Simply put, it meant making only what was needed, when it was needed, and in the amount needed.

The mysterious person who liaises with designers, adapts designs to suit production methods, sources fabrics, and accessories, undertakes quality evaluations of materials and responds to product queries, including complaints, from wholesalers and customers is the Garment Tech.

As a designer in the fashion industry, it’s a necessity to deal with factories and manufacturers. Knowing the difference between Specification sheet and Spec pack (often referred to as Tech Pack) and using them to your advantage can make or break your business.

The Pantone Matching System (PMS) is widely sued in the Fashion industry and was created to allow designers of any discipline to ‘colour match’ specific colours when a design enters production stage—regardless of the equipment used to produce the colour.

If in architecture you cannot build a good building without a blueprint, in the fashion you cannot create a product without a Specification sheet. Let’s learn all about Fashion Spec Sheet in this article.
Every successful fashion brand has a hidden pattern cutter in the background. Read why it is so important to have one and the types of pattern cutting available to designers today.

No matter how amazing your fashion product design may be, without a Tech Pack, and with no experience or knowledge of the industry, most factories will not take you seriously, deal with you or if they do, you will face countless problems. And yet so few fashion entrepreneurs know about it or know how to put one together.

Once upon a time, not that long ago, the word “logo” was synonymous to “brand”. Fast forward a couple of decades and today a “logo” is merely a shadow of a “brand”, but nowhere near what a “brand” is. Yet – not many people seem to make the distinction and realise this. Especially start ups.

If you have decided that finding an investor for your fashion business is the best option for you, here is some advice on how to prepare yourself to find the right one; whether you’re looking for a venture capitalist, an angel investor, a super-angel or a growth investor.

It is no secret that the fashion industry is predominantly a product-based industry. Success is often underpinned by great design, strong product and well-structured collections. Learn how to translate your ideas correctly into the products that you want.

Rarely does a new business start with enough money to last until a profit is turned. It might happen in the movies, but what happens in real life – more often than not – is that you start spending some or all of the capital you have raised.

Financing a fashion business is essential for success. Some businesses don’t require large capital at the start. Sadly for most fashion businesses. Learn how to fund your fashion start up.

Financing a business can come in many forms, but regardless of how you raise cash, more often than not you will be dealing with equity or debt. So, let’s explain what they are, and how they can work for or against us.

Imagine this – you have a great idea, you want to start your own business and everyone you tell is supportive and encouraging, and then they tell you firmly in a non-negotiable tone of voice, “You MUST write a business plan!”

We were fortunate enough to engage with the motivational force that is Rose Spinelli, a crowdfunding consultant based in America. She has been named among the ‘Top 100 Thought Leaders in Crowdfunding Today’.

Working in fashion is often not for the faint hearted. But starting your own business, your own brand – as some would say – that’s a different ball game.

Over the coming months, in addition to our regular interviews with our network of designers and manufacturers, and industry news scoops, Insider will introduce a regular series of articles on how to set up your own new fashion business.

Approaching fashion factories for the first time can be a nerve wracking experience, especially if you’re new to the fashion business